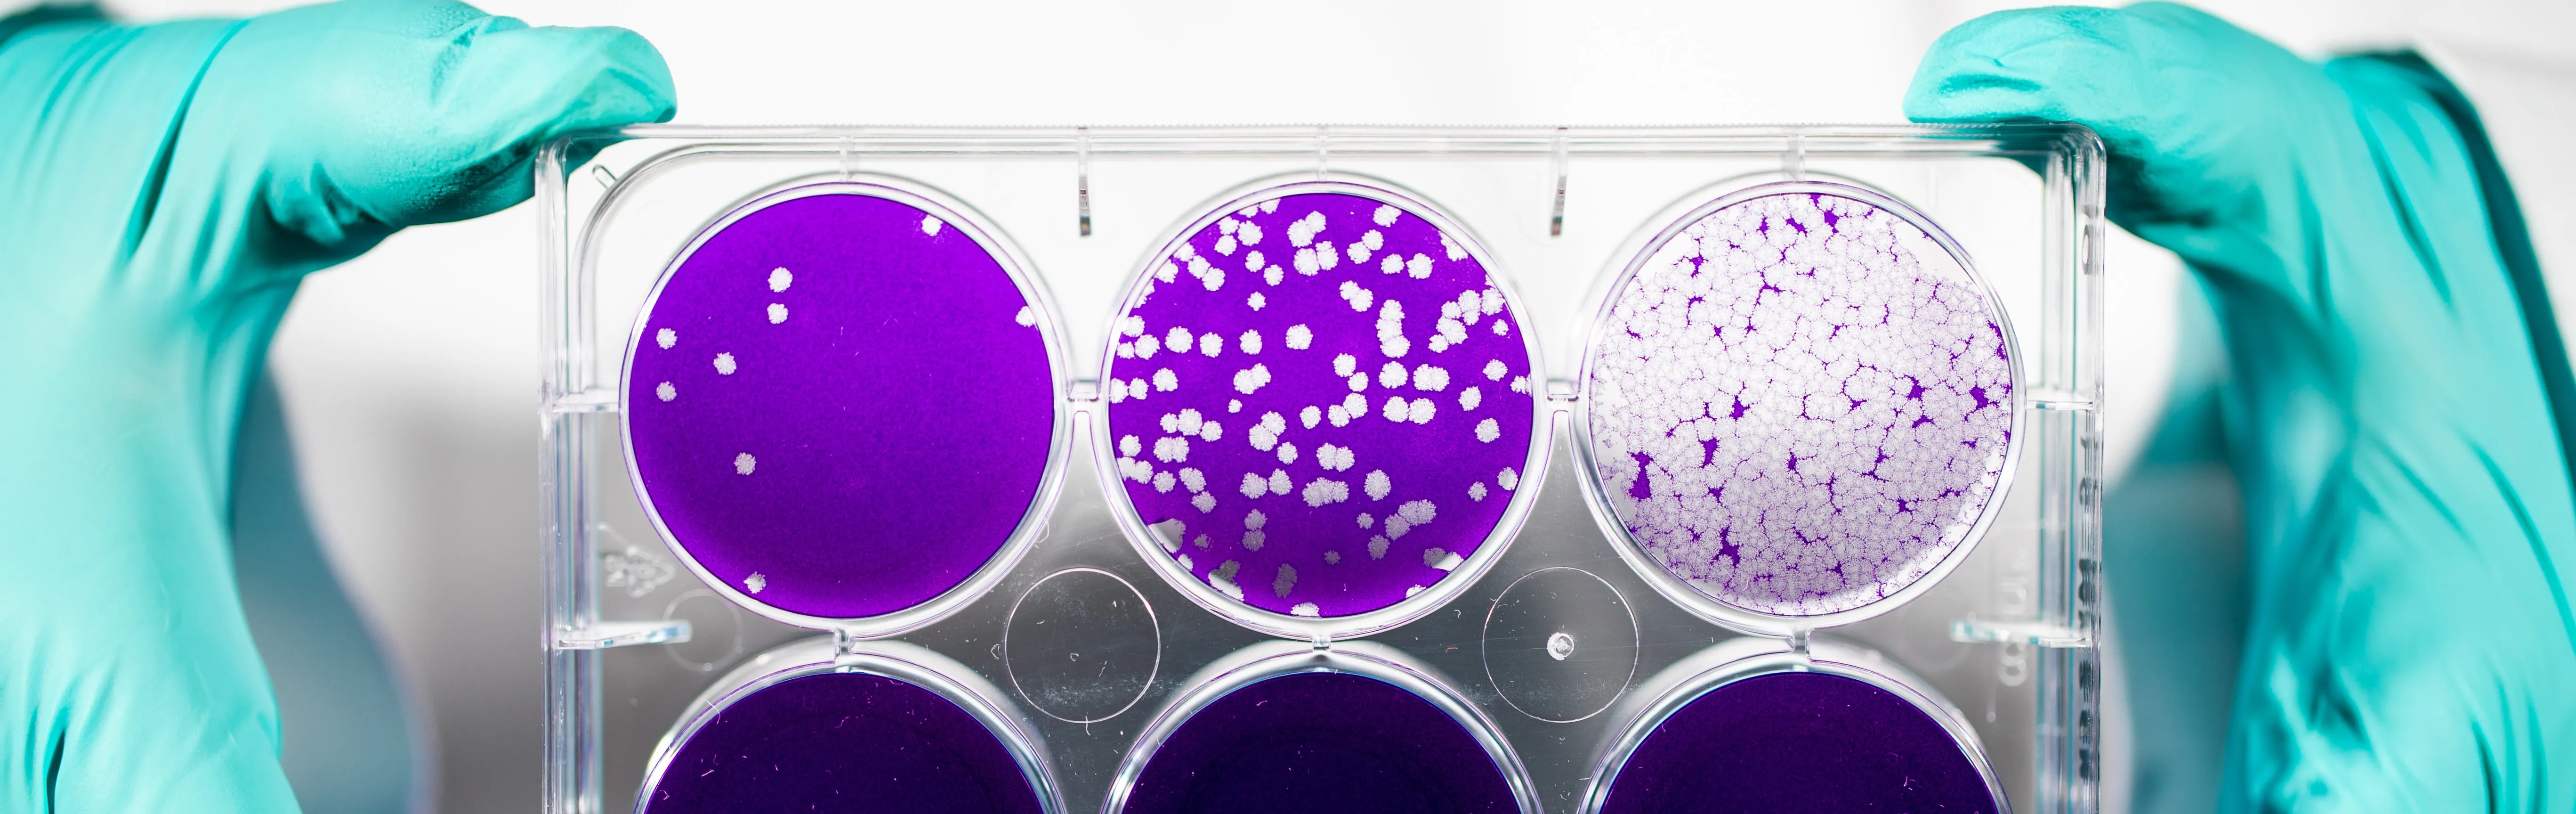
Immunology

Masters in Infectious Disease and Immunology
Microbial infectious diseases are among today's most challenging health issues
Pursue discoveries in microbial infectious diseases and immunology with a Master of Science (MS) in Infectious Disease and Immunology from Loyola University Chicago. This two-year, full-time research-intensive program partners with Loyola's Infectious Disease and Immunology Research Institute (InDIRI) to create a community of uniquely collaborative and integrated scientific researchers with expertise in bacterial and viral disease, host-microbe interactions, immunology, translational and implementation studies. With an MS in Infectious Disease and Immunology from Loyola, you will have a solid foundation to prepare for a variety of careers and/or advanced degrees in Biomedical Sciences.
Our Commitment To You
Program Learning Outcomes
Graduates will possess the following knowledge, skills, and professional values to begin a career in pharmaceutical or academic research, nursing, clinical lab science, science writing, forensic medicine, health care policy, and other biotech fields.
- A thorough understanding of the fields of infectious disease and immunology
- The ability to effectively read and interpret scientific literature
- The ability to discuss, develop and conduct projects that call for a broad training in the Biomedical Sciences and focused training in Infectious Disease and Immunology
- Technical expertise in molecular and/or cellular biology and a variety of other areas, such as Biochemistry, immunological techniques, enzyme assays, and cell culture
- The ability to design and conduct a biomedical research project from experimental design to protocol development and data analysis
- To act as a liaison to mediate collaboration between researchers and clinical faculty and in situations that require familiarity with clinical presentations within the areas of infectious disease and immunology
- Demonstrate strong communication skills for effective dialogues with colleagues, clients, physicians, and research scientists
- Strong verbal presentation skills for presenting research to clinicians, researchers, and the public
- Incorporate high standards of ethics into research design and execution, and data interpretation and with respect to patient interaction and confidentiality
- The ability to contribute to the health sciences, medicine, and related areas in the public and private sectors
- Incorporate high ethical standards in research design and execution, data interpretation, and patient interaction and confidentiality
- Connect coursework and research to the realities of the clinical environment to establish an understanding and appreciation of the continuity of biomedical research from “bench-to-bedside-to community”
Curriculum
The MS curriculum provides rigorous training in the fundamentals of basic cellular and molecular biology, as well as infectious disease and immunology. Elective courses in advanced statistics and clinical trial management prepare students to play a role at the critical intersection of research and clinical environments.
Students are required to complete 30 credits, 12 of which must be in didactic courses. In addition to graded courses, students enroll in IDIM 492 (Research) and attend the Institute’s seminar series, and MIIM current literature sessions. Students will enroll in Thesis Supervision (IDIM 595) in their third semester.
FIRST SEMESTER
- Lab rotations
- BMSC 405 Ethics in Biomedical Sciences (1 credit)
- BMSC 410 Molecular Biochemistry (4 credits)
- BMSC 412 Cell Biology (4 credits)
- BMSC 416 Methods (1 credits)
- IDIM 501 InDIRI Seminar (0 credits)
10 Total Credits First Semester
SECOND SEMESTER
- IDIM 400 Infections and Immunology (3 credits)
- BMSC 402 Statistical Methods for Biomedical Sciences (3 credits)
- IDIM 418 Oral Presentation skills (1 credits)
- IDIM 492 Research (2 credits)
- IDIM 501 InDIRI Seminar (1 credit)
10 Total Credits Second Semester
THIRD SEMESTER
- IDIM 401 Infectious Diseases (2 credits)
- IDIM 501 InDIRI Seminar (1 credit)
- IDIM 502 Infectious Diseases Case Studies (1 credit)
- IDIM 595 Thesis Supervision (0 credit)
- MIIM 503 Current Literature (1 credit)
5 Total Credits Third Semester
FOURTH SEMESTER
- IDIM 403 Parasitology and Virology (2 credits)
- IDIM 501 InDIRI Seminar (1 credits)
- IDIM 502 Pillars of Immunology (1 credit)
- MIIM 503 Curent Literature (1 credit)
- IDIM 595 Thesis Supervision (0 credits)
5 Total Credits Fourth Semester
__________________________________________
30 Total Program Credit Hours
RESEARCH
During the first semester, students will consult with faculty mentors and the program director to select one to three, six-week rotations to conduct research in a lab. MS candidates are expected to conduct an independent, original, experimental study resulting in a significant contribution to knowledge. The research will culminate in a thesis (and its successful defense) before the MS Thesis Committee.
Students conduct translational research projects with InDIRI faculty, under the direction of two scientific mentors: a basic scientist and a clinician. Aligned with the National Institutes of Health’s Roadmap for Medical Research, which emphasizes translational research, our program provides students with training that prepares them for careers in and outside of the lab.
FINAL THESIS
By the beginning of August in the second year, and after consulting with mentors, students will select a committee (comprised of the two mentors and two other faculty) and submit a written proposal for their master’s thesis. Following approval of the proposal, students continue to conduct experiments, write their thesis and defend it before the committee by the end of July in the second year. Students pursue research throughout the program, including during semester breaks.
GRAND ROUNDS
Students participate in the Department of Medicine’s weekly Clinical Grand Rounds and are expected to attend at least five, typically in their second year. This required participation allows students to interact with physicians, residents, and medical students. Students graduate with a thorough understanding of the language physicians use and the environment in which they and physician-researchers work.
Course Catalog
Admission
Ready to apply? This is a good place to start.
DEADLINES
We accept applications for the MS in Infectious Disease and Immunology on a rolling basis. Early application is encouraged; we begin evaluating applications in early December. The application deadline is June 15; there is no application fee.
APPLICATION PROCESS
1. COMPLETED APPLICATION
- Apply online or mail application to:
Graduate and Professional Enrollment Management
Loyola University Chicago
820 N. Michigan Avenue, Suite 1200
Chicago, IL 60611
2. TEST SCORES
- Applicants must submit GRE scores (Verbal, Quantitative, and Analytical exams) from the past four years to Loyola University Chicago. Although not required, we recommend applicants take the Subject Exam in Cell and Molecular Biology. Applicants may also submit official MCAT scores (if available).
3. OFFICIAL TRANSCRIPTS
- Applicants should have completed at least a bachelor's degree. Transcripts for all undergraduate and graduate work are required for admission.
4. LETTERS OF RECOMMENDATION
- Applicants must submit three letters of recommendation.
5. STATEMENT OF PURPOSE
- Your statement of purpose should be a brief, one page statement that explains your interest in this program.
6. INTERVIEW
- A personal interview is required. International applicants can interview via phone or video conference.
Please note: the only documents that cannot be uploaded with an application are transcripts and official test scores. Please send those documents directly to: gradapp@luc.edu.
INTERNATIONAL APPLICANTS
International applicants must have a degree equivalent to a U.S. Bachelor's degree and are required to submit the above documents and:
- TOEFL or IELTS scores
- A Declaration and Certification of Finances Form
- Evaluations of international transcripts by the Educational Credential Evaluators (ECE) is required. Read information about this service and download an application.
Please note: the only documents that cannot be uploaded with an application are transcripts, official test scores, and transcript evaluations. Please send those documents directly to: gradapp@luc.edu
Questions? Email Student Program Recruiter Donna Buczek.
Request more information about Loyola University Chicago graduate programs
FAQs
WHAT IS THE DIFFERENCE BETWEEN THE MS IN INFECTIOUS DISEASE AND OTHER GRADUATE OR MASTER'S PROGRAMS?
The MS in Infectious Disease and Immunology is distinct. First, it is a full-time, research-intensive training experience in which students are guided in a significant project by two mentors: a basic scientist and s clinician scientist. Additionally, the curriculum provides a rigorous foundation in molecular and cellular biology, as well as in advanced topics in infectious disease and immunology. We expose our students to the medical school curriculum, providing unique insights into that training.
IS HEALTH INSURANCE REQUIRED?
Students must provide proof of health insurance. Group health insurance is available through Loyola.
IS HOUSING AVAILABLE?
While the Health Sciences Campus does not offer housing, there are a variety of affordable options near campus, all within easy access to public transportation.
IS THIS A GOOD PROGRAM IF I WANT TO GET INTO MEDICAL SCHOOL?
While this program does not have any formal pipelines into medical school, many of our graduates pursue medical school. Our graduates also pursue PhD and nursing programs.
WHAT ELSE CAN I DO WITH THIS DEGREE?
Our program provides a very strong foundation for a variety of advanced degrees in Biomedical Sciences, including the PhD, MD, and nursing degrees. The program supports such a diverse range of educational opportunities because the training is highly rigorous in course work and bench research. Beyond further education and directly upon earning their degree, graduates are successful in research careers in industry, academia, and government labs.
WHERE IS THIS PROGRAM LOCATED?
Students study at Loyola University Chicago's Health Sciences Campus in Maywood, about 13 miles west of downtown Chicago. The campus includes the Stritch School of Medicine and its Biomedical Sciences graduate programs, the Marcella Niehoff School of Nursing, the Parkinson School of Health Sciences and Public Health, the Cardinal Bernardin Cancer Center, and Loyola Medicine, the University's academic medical center partner.
CAN I ENTER THE PROGRAM DURING THE SPRING SEMESTER?
No. We admit students in the Fall only; classes begin in August.
CAN YOU TRANSFER MY STRITCH SCHOOL OF MEDICINE APPLICATION DOCUMENTS TO YOUR PROGRAM?
Unfortunately, the Stritch School of Medicine has a different application process than Loyola's Graduate School.
I HAVE LOW GRE SCORES BUT A HIGH GPA. SHOULD I APPLY TO THIS PROGRAM?
Always consider applying. Once we receive your application, we will evaluate your application comprehensively (GRE scores, GPA, letters of recommendation, and research experiences).
HOW MANY STUDENTS DO YOU ADMIT TO EACH CLASS?
We expect to recruit between five and 10 students each fall.
CAN LOYOLA WAIVE THE GRE TEST REQUIREMENT?
While we cannot waive the GRE test requirement, we will accept your MCAT results instead of the GRE.
WHAT IS YOUR GRE CODE?
Our GRE code is 1412.
WHAT SHOULD THE STATEMENT OF PURPOSE INCLUDE?
The statement of purpose should include information about how you have prepared for and why you want to pursue this degree.
Tuition and Financial Aid
Loyola University Chicago's Graduate School and its Financial Aid Office are committed to helping students secure the financial resources to make their education at Loyola affordable.
Faculty

St. Albert's Day 2025
Salutes student research in the Graduate School, Stritch School of Medicine, Marcella Niehoff School of Nursing and Parkinson School of Public Health.

Super Resolution Microscope
Super-Resolution Microscope acquired by Health Sciences Campus is a game-changer for research in Loyola's Graduate Biomedical Programs.

Researchers Uncover New Antiviral Targets
Loyola Chicago Researchers Uncover New Antiviral Targets in Cellular Metabolism
Pursue discoveries in microbial infectious diseases and immunology with a Master of Science (MS) in Infectious Disease and Immunology from Loyola University Chicago. This two-year, full-time research-intensive program partners with Loyola's Infectious Disease and Immunology Research Institute (InDIRI) to create a community of uniquely collaborative and integrated scientific researchers with expertise in bacterial and viral disease, host-microbe interactions, immunology, translational and implementation studies. With an MS in Infectious Disease and Immunology from Loyola, you will have a solid foundation to prepare for a variety of careers and/or advanced degrees in Biomedical Sciences.
